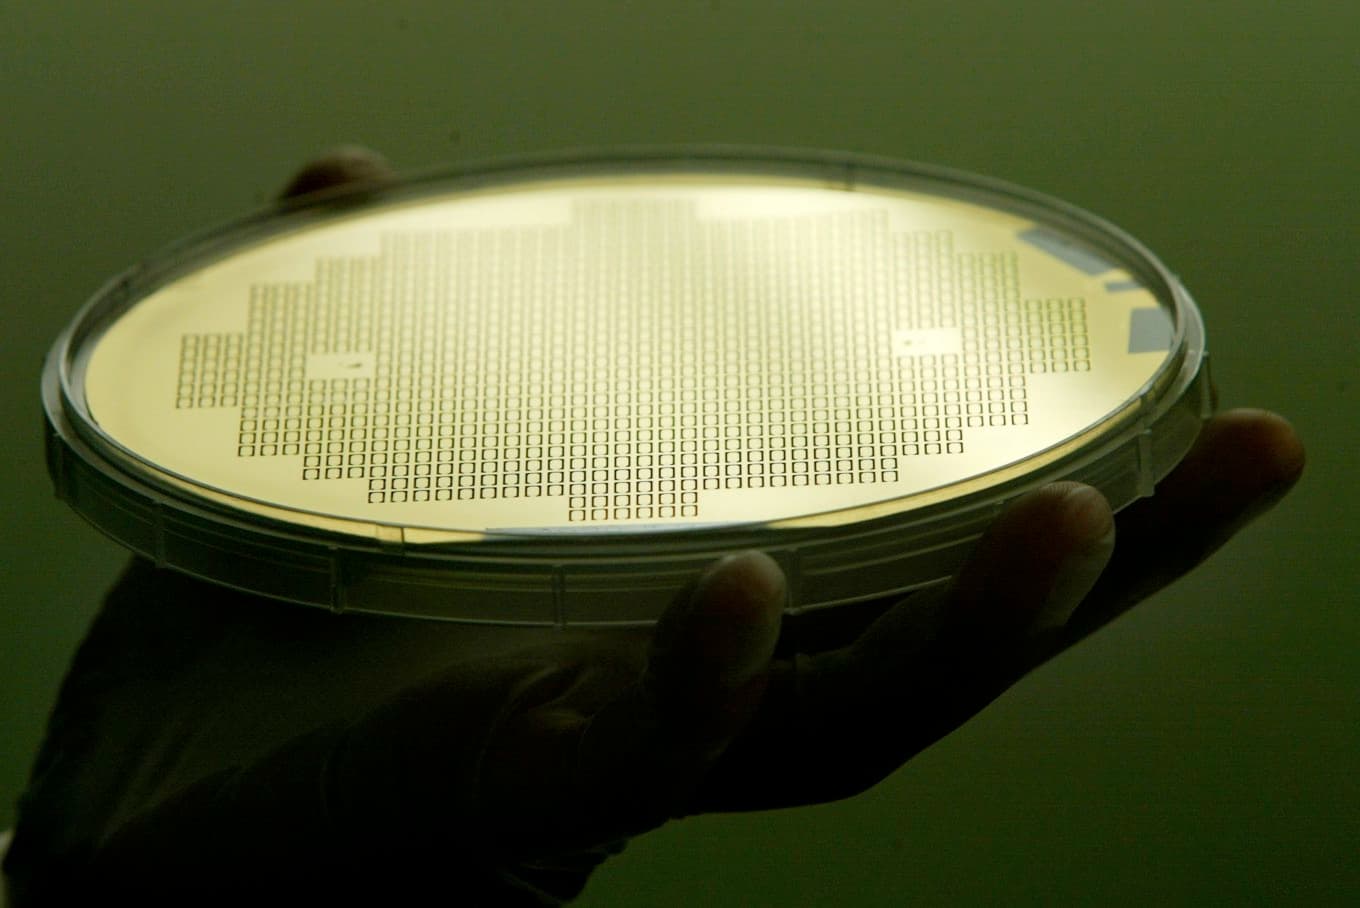
20040823 STOCKHOLM - Företaget Silex tillverkar mikrochip. Foto: Sofie Wiklund
COPYRIGHT PRESSENS BILD

Ansiktsmask med åkerfräken
Åkerfräken innehåller mycket kisel som är nyttigt för huden. Eftersom den är ganska sträv att ta i fungerar växten bra som skrubb i en ansiktsmask. Gör så här:
1 msk torkad söndersmulad åkerfräken
1 msk mald sötmandel
2 msk fet turkisk yoghurt
Foto: Eva Sagerfors
Blanda alla ingredienser och låt masken stå och dra i 10 minuter.
Tvätta ansiktet med varmt vatten, torka med handduk och bred sedan ut masken.
Låt den sitta på i 5-10 minuter och skrubba sedan igenom ansiktet med mjuka rörelser.
Skölj av och smörj in ansiktet med en fin ekologisk kallpressad olja, till exempel mandelolja eller min personliga favorit nyponfröolja.
Åkerfräken mot håravfall
Jag fick en fråga om vad man kan göra mot håravfall, och här kommer svaret:
Åkerfräken innehåller mycket kisel som stärker håret och hårbotten. Man kan göra en kur där man dricker tre koppar te på åkerfräken om dagen i en månad. Massera också in hårbotten med åkerfräkente några gånger i veckan. Det är också bra att skölja håret med brännässelte, som innehåller mycket kisel, andra mineraler och vitaminer.
Så här gör man åkerfräkente (det är lite speciellt):
Ta 2 msk torkad eller 4 msk färsk åkerfräken till 1 liter vatten.
Puttra under lock i 20 minuter.
Sila, och häll i en termos.
Plocka åkerfräken
Ska du plocka åkerfräken - beväpna dig med en riktigt bra flora och titta efter följande kännetecken:
1. Åkerfräken får ett sporbärande skott som växer upp på våren (brun pinne med kotte i toppen). Skottet vissnar sedan ner och ett sterilt grönt skott med grenar växer upp. Hos kärrfärken sitter kotten i toppen på det gröna skottet. Hittar du en fräken med kottar i toppen är det alltså inte åkerfräken.
2. Åkerfräken växer på torra platser medan kärrfräken växer på fuktiga platser. Jag har dock hittat båda arterna på samma plats flera gånger, så var uppmärksam på vad du plockar!
3. Åkerfräken innehåller mycket kisel och känns sträv att ta i. Gnuggar man den mellan fingrarna nära örat hör man ett tydligt gnissel eller prassel. Kärrfräken känns halkig att ta i och gnisslar inte.
Foto: Eva Sagerfors
4. Längs hela stammen växer grenarna ut i en cirkel med jämna mellanrum. Där grenarna växer ut finns runt stammen en rad med svarta tänder, nästan som en liten prinsesskrona. Fräkengrenarna är ledade som fingrar. Håll upp en fräkengren mot stammen och jämför längden på första grenleden, den närmast stammen, mot de små svarta tänderna. Hos åkerfräken är första grenleden längre än tänderna, hos kärrfräken är tänderna mycket längre än första grenleden. Kärrfräkentänderna är dessutom ofta svarta och grova och ser lite ondskefulla ut. Jag tänker: "Stora tänder - farlig. Små tänder - snäll."
Är du osäker - plocka inte!
Alexandra De Paoli är utbildad örtterapeut och journalist, men har lärt sig om växters effekter på kroppen sedan 7-årsåldern. Sedan 2005 medverkar hon som örtexpert i livsstilsprogrammet Strömsö. Förutom de kunskaper hon har genom egen erfarenhet studerar hon tillgänglig forskning om örter och deras verksamma substanser. Från 2019 är hon även medlem i EU-kommissionens fokusgrupp om medicinalväxter. Genom sitt arbete vill hon inspirera fler att prova läkeväxter som komplement till annan medicin.
Texten publicerades ursprungligen på Alexandras blogg.
Hjälp oss att driva tidningen vidare!
En donation till Epoch Times gör stor skillnad. Världen utsätts ständigt för vilseledande information. Epoch Times står för sanningsenlig och ansvarsfull journalistik. Vi bevakar viktiga nyheter som annars kan ignoreras. Vi vill ge våra läsare ett bredare perspektiv av vad som pågår i vår värld. Varje bidrag, stort som smått, räknas. Vi uppskattar verkligen ditt stöd! Här ser du hur du kan stödja oss.